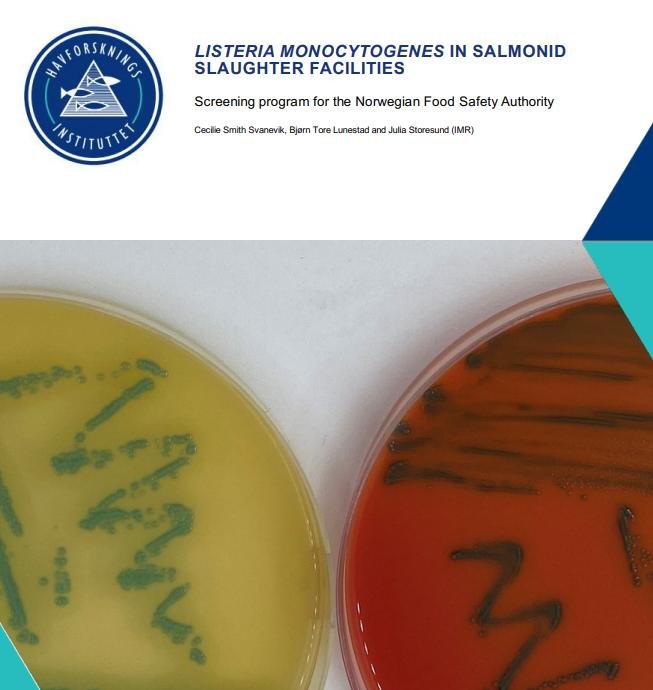
Belgium blog Feb 2022 #9

Listeria Warning this Xmas – avoid smoked Scottish salmon! https://t.co/vuyQxSimm8 @FSScot @foodgov @STJAMESSMOKE @ScotlandSalmon @sainsburys @Tesco @waitrose @AldiUK @LidlGB @marksandspencer @Morrisons @asda @TheGrocer @foodsafetynews #Listeria pic.twitter.com/w4P8AmHByw
— Don Staniford (@TheGAAIA) December 19, 2022
The Daily Telegraph reported (17 December 2022):
Warning over eating salmon this Christmas amid listeria outbreak https://t.co/xmcIQm6svp @ScotlandSalmon @STJAMESSMOKE @MowiScotlandLtd @scotseafarms @LochDuartSalmon @FSScot @TheGrocer @sainsburys @Tesco
— Don Staniford (@TheGAAIA) December 17, 2022
The Ross-Shire Journal reported (17 December 2022):
"As we approach the peak of the festive season, we know consumers are more likely to eat smoked fish, such as smoked salmon & trout. FSS & FSA are reminding vulnerable consumers of the advice more generally around consuming smoked fish" @FSScot https://t.co/TL8qYtgrNW #Listeria
— Don Staniford (@TheGAAIA) December 18, 2022
The Food Standards Agency reported (16 December 2022):
Food Safety News reported (20 December 2022):
A fatal Listeria outbreak in the United Kingdom has been traced to a salmon-smoking processing factory in Scotland @foodsafetynews @STJAMESSMOKE @FSScot @foodgov @ScotlandSalmon @JoannaBlythman @TheGrocer @IntraFish @salmonfarming1 @fishfarmermag https://t.co/9glU1IphXp
— Don Staniford (@TheGAAIA) December 20, 2022
Food Safety News reported in November 2022:
Intrafish reported in September 2022:
Who wants to play Listeria Roulette? 14.3% of Scottish salmon in 2019 tested positive with 50% of Danish salmon positive in 2020 & 10% of Chilean salmon positive in 2021 https://t.co/IdP3fDtmNZ @seafoodnorway @SummaEquity @LeroySeafood @SalmonChile @SoilAssociation @FSScot pic.twitter.com/LckkDFRnIa
— Don Staniford (@TheGAAIA) September 23, 2022
BBC News reported in September 2022:
Food Safety News reported in September 2022:
Food Safety News reported in August 2022:
Jewish News reported in July 2022:
Food Safety News reported in June 2022:
Food Safety News reported in April 2022:
The Brussels Times reported in February 2022:
Supermarkets Cora, Match & Smatch have recalled packs of Scottish smoked salmon due to Listeria contamination https://t.co/gRpaGN0JyX
The photo used on the offending packaging is of Eilean Donan castle where they filmed Highlander & the loch where @MowiScotlandLtd farm salmon pic.twitter.com/wK7uK5ODFd— Don Staniford (@TheGAAIA) February 6, 2022
Food Safety News reported in December 2021:
Read the Norwegian Food Safety Authority report in full online here
A scientific paper – 'Smoked salmon industry practices and their association with Listeria monocytogenes' – published in the journal of Food Control in January 2014 highlighted the risks of listeria contamination in Scottish salmon farming:
The Sunday Times reported in 2013:
The Sunday Times reported in 2004:
Another article published in The Sunday Times in 2004 reported:
The Sunday Herald reported in 2003:
Read more via:
Food Alert: Listeria Contamination of Scottish Salmon – Is Mowi the guilty party?
Listeria Contamination in Farmed Salmon
Farmed & Dangerous Salmon – the most contaminated food on the supermarket shelf
FDA Health Warning for Scottish Farmed Salmon
Death Toll Rises to Three – 950 People Infected from Farmed Salmon!
Norwegian Farmed Salmon: the Source of the Salmonella Outbreak?
Sicko Salmon – ABC News on "Horrible" Norwegian Farmed Salmon
Food Alert: Listeria Contamination of Scottish Salmon – Is Mowi the guilty party? https://t.co/vybX02bJBM@MowiScotlandLtd @1EileanDonan @foodgov @FSScot pic.twitter.com/TjoNEwvPYL
— Don Staniford (@TheGAAIA) February 8, 2022